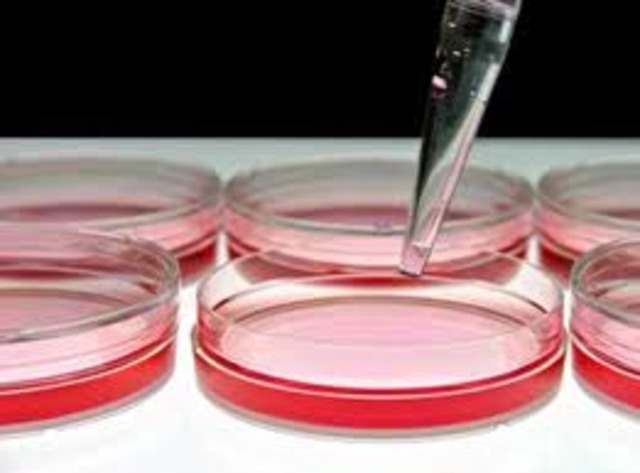
Robert Koch Develops the Culture Plate Method to Identify Pathogens

-
Hippocrates was born in 460BC and died in 370BC. Hippocrates theories in "On the Physician" were his ideas of the proper behaivor for someone in the medical profession. His ideas are still practiced today as the Hippocratic Oath
-
The Egyptian time period was 3500-500B.C.E. They were the first kown people to have accurate health records. The picture shown is a diagnosis and treatment of injuries.
-
Emphasis was placed on saving the soul and the Study of Medicine was prohibited during the dark ages. Any medical practices were banned and anyone caught was severely punished or killed (body dissections on criminals began).
-
-
Leonardo Da Vinci was the first artist who used dissection to draw the human body.
-
William Harvey described the ciruclation of blood flow.
-
-
-
-
Jenner's work represented the first scientific attempt to control an infectious disease by the deliberate use of vaccination.
-
the first ones were made of wood and brass.
-
-
Louis Pasteur began Pasteurizing MIlk to Kill Bacteria. He also began many experiments involving vaccinations and immunizations with Polio. For his first experiment, he took a small ammount of Polio and put it into young child's cut, and his body was able to arm itself to fight against the disease in the future. This was the first vaccination.
-
Gregory Mendel established the patterns of heredity by experimenting on pea plants.
-
-
-
-
-
Marie Curie isolated radioactive radium salts from the mineral pitchblende in their laboratory in Paris in 1910.
-
Acupuncture was used to help relieve pain and congestion in patients
-
ended in november 11, 1918
-
-
ended in 1945
-
this happened during world war 2
-
the big advantage of this new trchniquie is that there i no need to make a lare incision.
-
ends in july 27, 1953
-
Jonas Salk
-
Ended in april 30 1975
-
mircosurgeries is surgery on minute body sturcture or cells preformed with the aid of a microscop and other specialized instruments, suchs as micromanipulator.
-
built in two nights to stop spread from north and south korea
-
-
used a donor heart and placed it into a patients hearts that was failing.
-
-
Brown's parents had been trying to conceive a child for 9 years, and had no luck. Louise Brown still gets followed around today, because people are still expecting something to go wrong with her.
-
-
-
-
when obama became president it showed that rasicm was not a big deal anymore
-
The insertion of genes into an individual's cells and tissues to treat a disease, hereditary disease in particular.
-
Diagnostic and screening medical procedures specifically developed to promot health and wellness.
Want to make a timeline like this?
Use Timetoast to turn dates, events, milestones, and phases into a clear visual timeline you can build and share. Timetoast is a timeline maker for work, school, research, and stories.